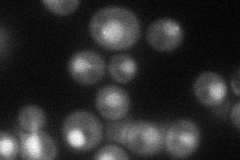
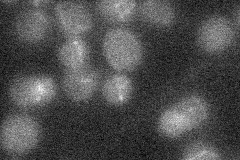

View description
Deoxycytidyl transferase, forms a complex with the subunits of DNA polymerase zeta, Rev3p and Rev7p; involved in repair of abasic sites in damaged DNA
Localization:
Intensity:
Fold change:
Significance:
-
C’ GFP library in SD

nucleus18.72 -
N' NOP1pr-GFP in SD
nucleus51.07 -
N' TEF2pr-mCherry in SD

nucleus11.8033 -
N' NATIVEpr-GFP in SD
below threshold18.7862 -
N' TEF2pr-VC and Cyto-VN in SD

below threshold23.7913 -
C’ GFP library in SD+DTT

cytosol16.330.87No -
C’ GFP library in SD+H2O2

nucleus20.91.11No -
C’ GFP library in Starvation Media

cytosol15.620.83No -
C’ GFP library on the background of Pup2-DaMP

nucleus -
C’ GFP library on the background of CCT mutant

nucleus17.18390.917236No
